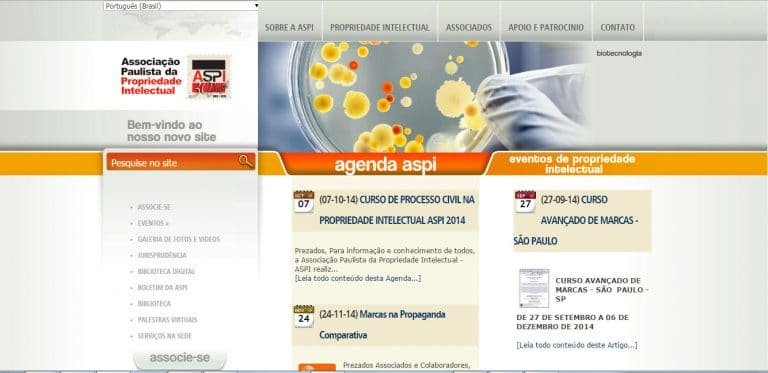

Associações integradaspela Peduti Advogados
I2AI - A Connected AI World
Tv. Dona Paula, 13 - Higienópolis, São Paulo - SP, 01239-050
(11) 99911-4000
https://www.i2ai.org
ASSOCIAÇÃO DE ESCRITÓRIOS DE ADVOCACIA EMPRESARIAL
Av. Paulista, 2073 – Conjunto Nacional Horsa I
2º andar, Sala 201
Bela Vista CEP 01311-940 – São Paulo – SP
Fone : +55 11 3266-3667
adm@redejur.com.br
www.redejur.com.br
ASSOCIAÇÃO PORTUGUESA DE DIREITO INTELECTUAL
Tel: 21 796 7562 (Direto)
21 798 46 00 (FDL)
www.apdi.pt
ASSOCIAÇÃO DOS ADVOGADOS DE SÃO PAULO
Rua Álvares Penteado, 151 – Centro
São Paulo – SP – 01012-905
(11) 3291-9200
http://www.aasp.org.br/
ASSOCIAÇÃO PAULISTA DA PROPRIEDADE INTELECTUAL
Av. Professor Ascendino Reis, 1548, CEP: 04027-000, São Paulo, SP, Brasil.
+55 (11) 5575 4944 / 55 (11) 5571 8530
aspi@aspi.org.br
http://www.aspi.org.br/
CÂMARA ÍTALO-BRASILEIRA DE COMÉRCIO E INDÚSTRIA
Av. São Luiz, nº 50 – 16º andar – Cj. 161 ABC – CEP: 01046-926 – Centro – São Paulo-SP
+55 (11) 3123 2770 / +55 (11) 3123 2771
http://www.italcam.com.br/
ASSOCIAÇÃO BRASILEIRA DA PROPRIEDADE INTELECTUAL
Alameda dos Maracatins, 1217 – conj. 608 -Moema – São Paulo – SP – 04089-014
Tel.: (11) 3044-6613
http://www.abpi.org.br/
ASSOCIAÇÃO BRASILEIRA DE LICENCIAMENTO
Av. Pavão, 955 – Ed. Kuba, conj. 32 – 3º andar – Moema – São Paulo, SP
(11) 3021-7616 / (11) 5041-9087
http://abral.org.br/
CÂMARA PORTUGUESA
Av. Liberdade, 602 – 2º andar – 01502-001 – São Paulo – SP
+55 (11) 3340-3333 / +55 (11) 3340-3334
www.camaraportuguesa.com.br
INTERNATIONAL TRADEMARK ASSOCIATION
ButtonASSOCIATION INTERNATIONALE POUR LA PROTECTION DE LA PROPRIÉTÉ INTELLECTUELLE
ButtonLES BRASIL: LICENSING EXECUTIVES SOCIETY BRAZIL
LES BRASIL: licensing executives society Brazil
Rua Teófilo Otoni, 63/901
Centro | Rio de Janeiro, RJ
https://www.lesbrasil.org.br/
IRGLOBAL
UK Head Office The Piggery,
Woodhouse Farm, B92 0DJ
West Midlands, United Kingdom
Company No: 07254406
https://irglobal.com/